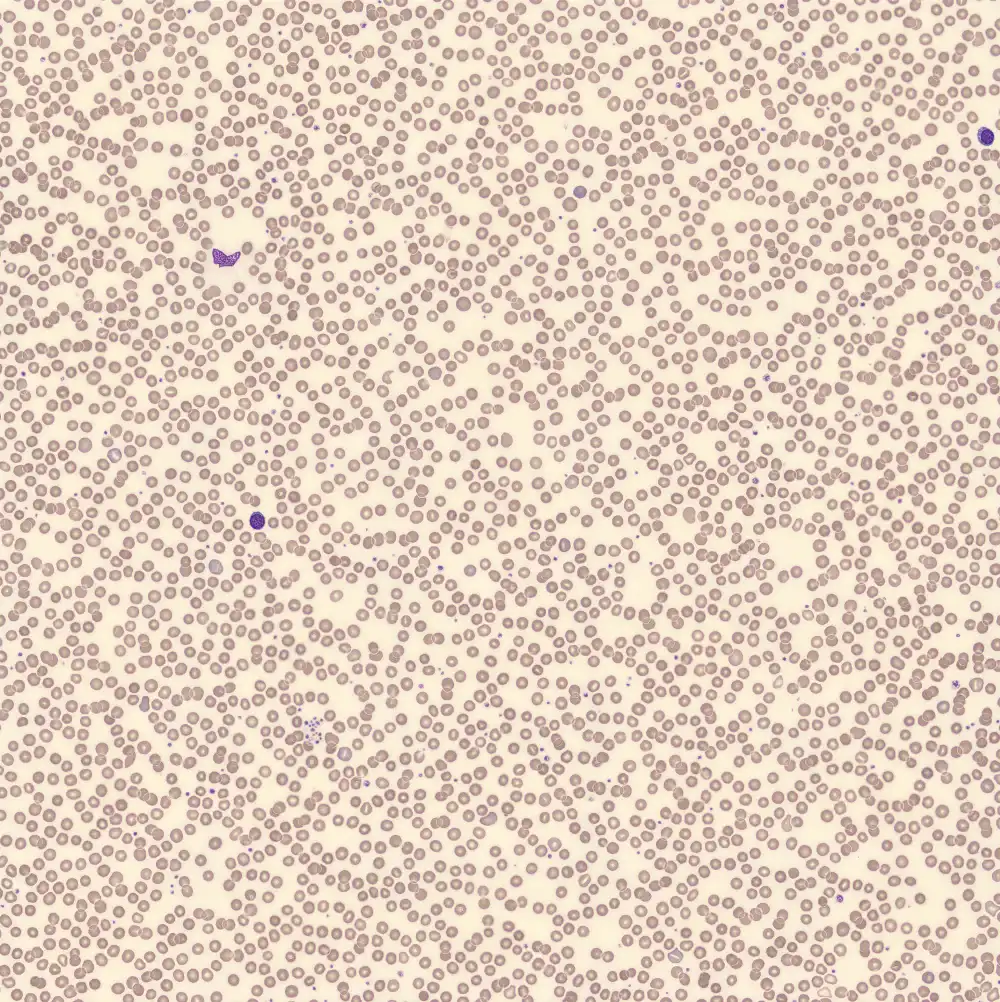

PCL - Slide 4
At diagnosis, the patient basically meets the criteria for multiple myeloma. However, because of the presence of more than 5% plasma cells in the peripheral blood, the diagnosis of primary plasma cell leukemia, the most aggressive form of plasma cell dyscrasias, was made. There was hypercalcemia of 3.5 mmol/L, with no impaired renal function and no anemia, but extensive osteolytic lesions in the upper body. In addition, an IgG-kappa paraprotein of 40 g/L was detected.
Neutrophils
Lymphocytes
Monocytes
Eosinophils
Basophils
Plasma Cells
XN Scatterplots
Immunophenotype
CD45-
CD19-
CD20-
CD38++
CD138+
CD56+
CD27-
CD81+
CD117-
Peripheral blood
Plasma cells











































































































































































